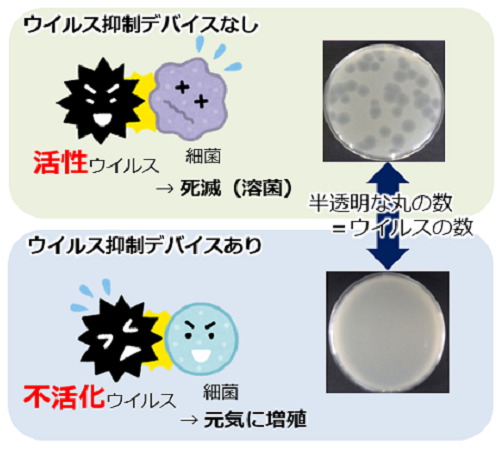

ウイルスに効くか知りたい!ウイルス抑制効果評価サービスのご紹介
2022年1月11日
信頼性ソリューション部 金田です。
新型コロナウイルスを身近に感じながら、気が休まらない日が続いており、皆さんも対策をしながらの生活を送られていることと思います。
身の周りの商品にも、「除菌対策済み」「抗ウイルス効果確認済み」等のキーワードが付いているものを目にする機会も増え、ウイルス対策機能が一般的になってきたのではないでしょうか。
今回は、“ウイルス抑制効果評価サービス”について紹介致します。
私達の評価サービスとして、菌だけでなくウイルスの抑制効果についても対応可能となっており、多くのお客様からご相談のお声がけをいただいています。

●こんな方に有用なサービスです!
- 生活空間(23m3)で家電商品を使った時のウイルス抑制効果(抗ウイルス効果)を確認したい方
➡試験例)一般社団法人日本電機工業会 ~空気清浄機の室内付着ウイルスに対する抑制性能評価試験方法~ - 光触媒や抗菌剤配合材料などのウイルス抑制効果(抗ウイルス効果)を確認したい方
➡試験例) JIS R 1706「ファインセラミックス− 光触媒材料の抗ウイルス性試験方法−バクテリオファージQβを用いる方法」 - その他開発中の商品や材料のウイルス抑制効果(抗ウイルス効果)を確認したい方
➡商品・材料特性に応じて、試験方法をご相談させていただきます。
では、日本電機工業会の試験法を例に、どのように定量するか、イメージ図で説明します。
《試験イメージ》(日本電機工業会の規格試験)
A)ウイルス抑制デバイスの曝露試験(下左図 A))
- ウイルスを試験片に塗布し、ウイルス抑制デバイスから所定の距離に設置。
- ウイルス抑制デバイスを作動させ、所定時間曝露。
B)ウイルス抑制効果の定量
- ウイルスは菌やカビとは異なり、ウイルス自身では増殖できないため、Aの試験後のウイルスを回収し、ウイルスが増殖のために侵入できる細菌と混合し培養。
- 生きているウイルス(活性ウイルス)は細菌に侵入し、侵入された細菌は死滅(溶菌)します。
シャーレ上の死滅した細菌は半透明に見えます。(下右図 B)ウイルス抑制デバイスなし)
一方、死んでいるウイルス(不活化ウイルス)は細菌に侵入できないため、細菌は増殖します。
そのため、シャーレは細菌に埋め尽くされて、真っ白に見えます。(下右図 B)ウイルス抑制デバイスあり)
1個のウイルスから1つの半透明の丸が作られるため、「細菌が死滅した部分(半透明な丸)の数=ウイルスの数」となり、ウイルス抑制効果を定量できます。
A)ウイルス抑制デバイスの曝露試験

B)ウイルス抑制効果の定量
見えないウイルスと戦い、お客様に安心を届ける商品にしてみませんか。
上記評価の他にも、
など、空質快適空間の評価も行っております。ぜひ、お気軽にお問合せください。



